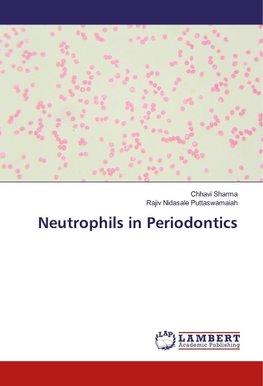
Neutrophils in Periodontics

-
 Anglický jazyk
Anglický jazyk
Neutrophils in Periodontics
Autor: Chhavi Sharma
Oral tissues are constantly exposed to microbial environment. A balance between bacteria and innate immune cells are maintained in healthy gingival tissue. Neutrophils create a barrier for bacteria to reach inside tissues. But paradoxically when neutrophils... Viac o knihe
Na objednávku
48.74 €
bežná cena: 51.30 €
O knihe
Oral tissues are constantly exposed to microbial environment. A balance between bacteria and innate immune cells are maintained in healthy gingival tissue. Neutrophils create a barrier for bacteria to reach inside tissues. But paradoxically when neutrophils persist for a longer period of time, they can also promote a chronic inflammatory state that leads to periodontitis. The presence of neutrophils in the GCF has been shown to reflect the inflammatory condition of the tissues and can be used as a reliable clinical index of disease activity. An interesting approach which is emerging in the fields of medicine is the development of the susceptibility profile, where several relatively common high-risk neutrophilic disorder could giving them a cumulative high susceptibility for a specific disease. For such a high-risk profile to be proved in periodontal disease, much testing across different populations would be needed. Such useful genetic information would be invaluable in therapeutic intervention strategies aimed at preventing the development of periodontal disease.
- Vydavateľstvo: LAP LAMBERT Academic Publishing
- Rok vydania: 2017
- Formát: Paperback
- Rozmer: 220 x 150 mm
- Jazyk: Anglický jazyk
- ISBN: 9786202023740





 Nemecký jazyk
Nemecký jazyk 



 Španielsky jazyk
Španielsky jazyk 


